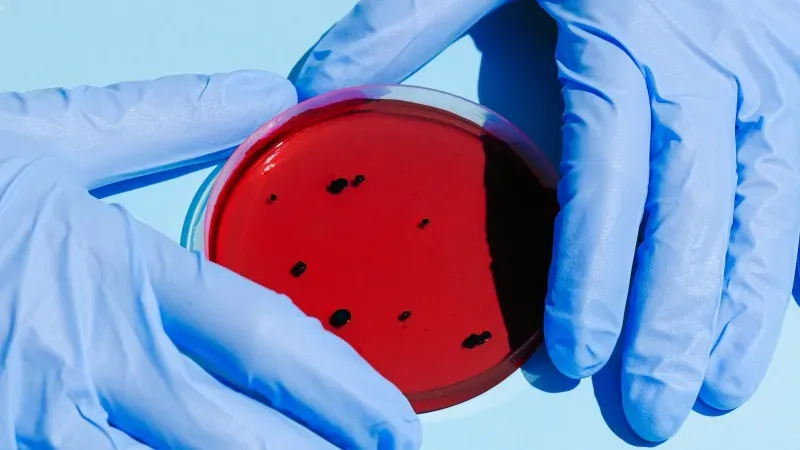

Infectious diseases, fast diagnostics drive clinical microbiology market
Asia-Pacific will see the fastest growth.
The global clinical microbiology market, valued at $4.8b in 2023, is projected to reach $9.7b by 2033, according to Allied Market Research.
Growth is being driven by the rising incidence of infectious diseases, including respiratory and bloodstream infections, as well as the increasing demand for faster, cost-effective diagnostic tools.
Advanced technologies such as molecular diagnostics, automated culture systems, and multiplex testing are further boosting market expansion.
High diagnostic costs and regulatory hurdles in some regions remain challenges, whilst the adoption of artificial intelligence and automated laboratory systems presents significant opportunities.
Amongst product segments, laboratory instruments, including microbial identification systems, molecular platforms, and mass spectrometry equipment, accounted for the largest market share in 2023, with automation and portable instruments increasing demand.
Respiratory diseases and bloodstream infections are the primary drivers of market growth, although urinary tract infections, sexually transmitted diseases, gastrointestinal disorders, and periodontal diseases also contribute as diagnostic tools improve.
Regionally, Asia-Pacific is expected to experience the fastest growth due to increased healthcare investments, a growing elderly population, and heightened awareness of infectious diseases, whilst LAMEA (Latin America, Middle East, and Africa) is projected to see steady growth supported by improved healthcare access and public health initiatives.

















 Advertise
Advertise









